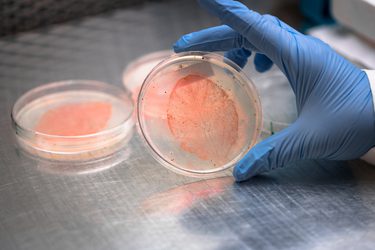
A petri dish

Reflecting on the Age of Adaptation
- Transition From CPU to GPU
- A Unipolar World to a Multipolar World
- Shifting From a Declining Price of Money to an Unknown Price of Money
- Moving From 1.5C Degrees to 2.5C Degrees of Warming
- From Demographic Dividend to Headwind, Fueled by an Aging Population
- What This Means for 2026 — Investment Priorities
I believe we are living in an Age of Adaptation, driven by five secular trends that will result in market dislocations in the coming years. The combination of these factors will redefine what beta looks like and what alpha opportunities exist in our sectors. As investors in food & agriculture, oceans and energy, it is crucial to reflect on the signals of these forces in 2025 and to assess the implications heading into 2026.
Transition From CPU to GPU
In 2025, it became clear that the world is shifting from traditional CPU-based computing toward GPU and accelerator-based computing as the new foundation for data centers and AI. Market analysts now expect AI processors to become a nearly half-trillion-dollar market by 2030, with GPUs accounting for the majority of that growth. This market growth indicates that most future computing power will come from accelerators rather than general-purpose chips. Industry reports describe this year as an inflection point, as companies like Nvidia, AWS, and others unveiled new generations of AI-focused chips and “AI factory” data centers designed around GPUs. A second wave of GPU shortages and new export controls underscored the tightness and geopolitical sensitivity of this supply chain. At the same time, studies in the real estate and power sectors have shown that GPU-dense data centers require significantly more electricity and cooling than conventional facilities, and that AI is becoming one of the most significant new sources of power demand worldwide.
For investors in food & agriculture, oceans and energy, this shift from CPU-centric to GPU-centric computing is a new demand center that affects both operating models and input markets. On the opportunity side, cheaper and more abundant GPU compute underpins the next wave of applied AI in S2G’s focus sectors, from field-level decision support and yield prediction in agriculture, to ocean mapping, fisheries management, supply chain optimization and physical risk analytics that price climate and geopolitical shocks into assets in real time. On the constraint side, the 2025 copper rally, which Reuters links partly to power and cabling needs for AI data centers, and new research on data center power demand and grid bottlenecks, signal that GPU-driven AI will be a major competitor for electricity, transmission capacity, cooling water and critical minerals that these sectors also depend on. Local pushback against large AI campuses, such as the Chandler, Arizona council’s rejection of a proposed AI data center, adds siting and permitting risk for energy and infrastructure projects that aim to serve both AI and real economy customers.
In practical terms, the transition to a GPU-centered world increases the premium on strategies that use AI to unlock productivity and resilience in food, oceans and energy, while also favoring assets and business models that can secure long-term access to power, grid capacity and critical materials in a landscape where AI infrastructure itself has become an anchor tenant in the industrial economy.
A Unipolar World to a Multipolar World
This year, geopolitics made it clear that the post-Cold War unipolar order is fading and a more contested, multi-node system is taking shape. The Munich Security Report 2025 explicitly describes a world in “multipolarization,” with power spread across more actors and deeper fractures between competing models of order. An expanded BRICS bloc, now including major energy and commodity players such as Saudi Arabia, the UAE, Egypt, Ethiopia and Indonesia, used the Rio summit to call jointly for IMF quota reform, greater use of national currencies and new guarantee mechanisms from the New Development Bank, a coordinated bid to rebalance financial and governance power toward the Global South. In parallel, Global South forums from Marrakech to Belém framed climate, food and energy security as arenas where Southern coalitions will set more of the rules, while the United States and China remained locked in strategic competition over trade, technology and supply chains rather than moving back toward a liberalized status quo.
For investors in food & agriculture, oceans and energy, this shift from “one center of gravity” to several means that security of access replaces simple price as the dominant variable. The United Nations’ Trade and Development Report 2025 highlights how concentrated markets and climate shocks already combine with debt stress to increase food insecurity in vulnerable countries, a risk that grows as blocs experiment with local currency trade, new grain exchanges and more frequent export controls. In energy and ocean-related infrastructure, McKinsey’s Global Energy Perspective and other 2025 security analyses highlight how geopolitical instability and rivalry over critical minerals, ports, and renewable supply chains are forcing governments and companies to diversify suppliers, regionalize value chains, and invest in redundancy in grids, storage, and logistics.
For S2G’s focus sectors, this multipolar world raises the premium on assets that improve regional food system resilience, reduce exposure to single route shipping and chokepoints, and secure less volatile energy and other critical inputs under a broader range of political scenarios, in other words, strategies that treat geopolitics as a structural factor in cash flows rather than a background headline risk.
Shifting From a Declining Price of Money to an Unknown Price of Money
In 2025, the macro environment moved from debating the future level of interest rates to navigating an uncertain and unstable price of money. Global institutions such as the IMF and World Bank describe a world marked by weaker medium-term growth, policy reversals, and elevated fiscal and geopolitical stress, conditions that drive repeated repricing of inflation and long-term yields. The Bank for International Settlements (BIS) and the Fed highlighted how high public debt and shifting term premia leave markets vulnerable to abrupt moves in financing costs, while global debt has climbed toward record levels with major refinancing walls ahead. Instead of a predictable glide path for monetary policy, investors now face a régime defined by volatility in funding conditions. For food & agriculture, oceans, and energy, this uncertainty directly influences capital formation, as many projects in these systems depend on long-term financing, stable cash flows, and confidence that debt markets will remain open at workable costs.
In North America, the implications are immediate because the region’s food, agriculture, oceans, and energy sectors are capital-intensive, climate exposed and deeply connected to credit conditions. Higher and more volatile interest rates influence farmland values, farm credit availability, and producers’ operating margins, which in turn slow equipment investment, expansion, and infrastructure upgrades across grain handling, cold storage, and processing. Fisheries and ocean infrastructure face similar pressure as the cost of vessels, hatcheries and insurance rises. In energy, even with strong policy support and abundant resources, the United States and Canada must contend with the higher cost of capital for grids, storage, renewables, transmission, hydrogen and carbon management, which can delay or reshape investment pipelines.
For investors, this environment raises the premium on lower leverage, contracted or inflation-linked cash flows, and capital structures that can absorb funding volatility. It also increases the strategic value of tools such as tax equity, credit enhancement and blended or catalytic capital, which help essential resilience and decarbonization projects move forward despite uncertainty over the true price of money.
Moving From 1.5C Degrees to 2.5C Degrees of Warming
In 2025, the scientific community has effectively converged on the thesis that we are not heading for a 1.5 degree outcome; we are tracking toward roughly 2.5 degrees of warming, which makes physical climate risk a core organizing principle for economies, companies, and portfolios. UNEP’s Emissions Gap work shows that even if current national pledges are fully implemented, the planet is still heading for roughly 2.5 to 2.9 degrees of warming this century, far above the Paris ambition. New analyses from Copernicus and others indicate that the three-year average for 2023 to 2025 is set to exceed 1.5 degrees above pre-industrial levels for the first sustained period, with 2024 already the first single year above that threshold, a signal that the 1.5 degree window is now more a political reference point than an operational base case.
At the same time, the damage profile is converging with this higher temperature world: NOAA records 27 billion dollar disasters in the United States in 2024, nearly triple the long term annual average, and Climate Central reports 14 such events costing more than 100 billion dollars in just the first half of 2025, with the Los Angeles wildfires alone exceeding 60 billion dollars and setting a new record for wildfire losses. Aon’s 2025 Climate and Catastrophe Insight report puts global economic losses from 2024 natural disasters at 368 billion dollars, with a protection gap of 75 percent for flood, which underlines how much of this 2.5 degree style risk is still uninsured. Together, these signals say that the central case has shifted, from trying to prevent a 1.5 degree world to financing resilience in a system that is likely to overshoot 2 degrees and drift toward 2.5.
For investors in food & agriculture, oceans and energy, this shift changes the core underwriting assumptions. In food & agriculture, more frequent heatwaves, droughts and extreme rainfall events raise yield volatility, disrupt input supply chains and stress water systems, and UNEP’s Adaptation Gap work now estimates that developing country adaptation needs are ten to eighteen times larger than current international public flows, which points to a large, undercapitalized pipeline for climate resilient crops, irrigation, storage and risk management tools. In oceans, the same warming trajectory implies more damaging marine heatwaves, stronger storms and accelerating coastal erosion, which increases the need for investment in resilient ports, coastal protection, sustainable fisheries and aquaculture that can cope with changing temperature and acidity regimes. In energy, a 2.5 degree path means both higher physical risk to grids, pipelines and generation assets, and faster growth in electricity demand as societies adapt with cooling, desalination and data infrastructure, and the IEA’s World Energy Outlook 2024 already shows global energy systems in transition but still on a trajectory that overshoots the Paris temperature goals.
For S2G’s focus areas, the implication is that adaptation and resilience are not side themes; they are central drivers of value, favoring companies and assets that can protect real economy cash flows under higher physical risk, monetize efficiency and loss avoidance, and tap blended or innovative finance structures to build the infrastructure a 2.5 degree world will require.
From Demographic Dividend to Headwind, Fueled by an Aging Population
In 2025, demographic trends that once provided a growth dividend shifted decisively toward becoming a structural headwind. The IMF describes this pivot as a move from “demographic dividend” to “demographic drag,” as the share of working-age people contracts and older populations expand across advanced and middle-income economies. UN population projections indicate that the global share of people aged 65 and older has nearly doubled since the mid-1970s and is expected to double again by the 2070s, while most countries now have a fertility rate below replacement levels. OECD analysis warns that aging will reduce the working-age population by about eight percent across member nations by 2060, lowering potential growth and requiring significantly higher public spending. This demographic shift also drives healthcare expenditures sharply upward, tightening fiscal space and household budgets as a greater share of resources is absorbed by medical and long-term care. Combined with slower growth, these pressures reduce the fiscal capacity available for food system resilience, coastal infrastructure and energy transition investments. At the same time, they make labor scarcity more acute.
For investors in food & agriculture, oceans and energy, these demographic realities are already shaping the operating environment. Agriculture is among the oldest workforces in North America and Europe, with roughly one-third of American farmers and ranchers now over 65 and industry data highlighting persistent labour shortages tied to an aging workforce and limited entry by younger producers. Similar dynamics appear in global fisheries and coastal infrastructure roles that rely on skilled, aging operators. Energy faces pronounced talent constraints as well, with the IEA’s World Energy Employment analysis showing that retirement-eligible workers greatly outnumber new entrants in key grid, nuclear, and engineering roles that are essential for a resilient transition. The simultaneous rise in healthcare costs amplifies these challenges by reducing the disposable income of rural and coastal households and constraining government budgets that support critical food, water and energy infrastructure.
For S2G’s focus sectors, this means that strategies relying on abundant low-cost labor or expanding public support are increasingly misaligned with demographic reality. Instead, investment must flow toward automation, robotics, decision support tools that augment scarce workers, and business models that lower operating costs and maintain productivity in societies where aging is a central economic constraint rather than a distant concern.
What This Means for 2026
The common thread across the five forces defining the Age of Adaptation is that our food, agriculture, oceans and energy systems are becoming more volatile, more capital-constrained and more strategically important, which elevates the value of assets and technologies that deliver resilience, security and productivity.
For 2026, this points to a clear set of investment priorities aligned with our thesis.
Resource Efficiency
Investments that help food, agriculture, oceans and energy systems produce more with fewer inputs will gain importance as the world moves toward 2.5 degrees of warming and faces rising costs of capital and labor. Priority areas include climate-resilient crops, water-efficient production, controlled environment agriculture, energy-efficient processing and storage, grid hardening, coastal resilience, and technologies that reduce losses and emissions across supply systems. These solutions become essential as aging demographics, higher healthcare spending and climate volatility compress public budgets and household incomes, making efficiency a primary driver of value creation.
Mass Digitalization
The shift from CPU to GPU-driven compute, along with accelerating AI adoption, creates new opportunities to digitize real-economy systems at scale. Key investment areas include precision agriculture platforms, biological design tools, ocean and fisheries monitoring, climate and physical-risk analytics, predictive maintenance for energy and water infrastructure and automation that augments scarce labor. As AI data-center power demand expands, investors will also need to focus on digital infrastructure that integrates efficiently with local grids and supports resilient and sustainable growth.
Agile Supply Chains
A more multipolar world and repeated climate disruptions elevate the need for supply chains that are regionalized, diversified and responsive. Investments should support secure and flexible sourcing of fertilizers, feeds, proteins, critical minerals and clean-energy components; modernized logistics and cold chain networks; resilient port and coastal infrastructure; and traceability systems that enhance reliability under geopolitical and climatic stress. Agility becomes a competitive advantage when trade routes shift, weather shocks intensify and capital markets remain volatile.

The Conscious Consumer
Aging populations, rising healthcare costs and climate-related shocks are reshaping consumer behavior toward products that improve health, affordability and environmental impact. This drives investment opportunities in sustainable proteins, nutrient-dense and functional foods, reduced-waste packaging, transparent food systems and low-carbon energy solutions that help households manage cost and risk. Companies that align with consumer demand for healthier, more sustainable and more resilient choices will be better positioned as these pressures compound.

My perspectives on the Age of Adaptation are also covered in my original report “The Age of Adaptation” and S2G Podcast episode “Navigating the Age of Adaptation.” You can also follow me on LinkedIn, where I will be sharing additional commentary on these topics in 2026.